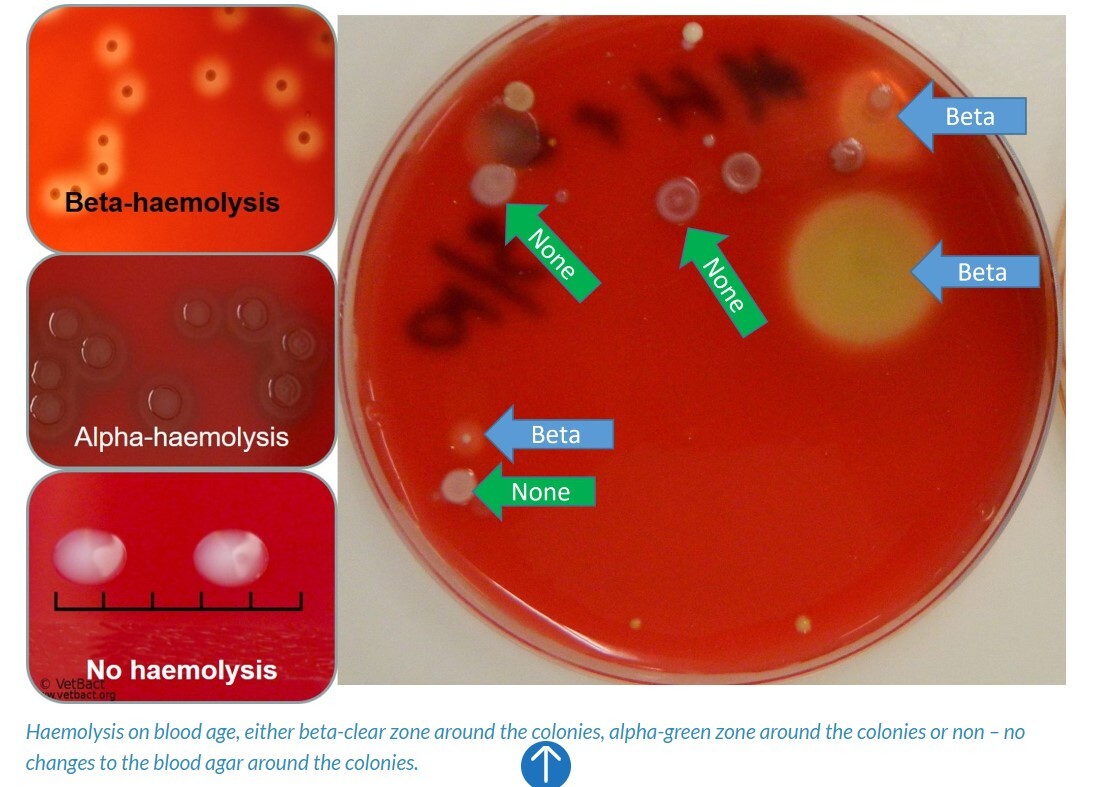
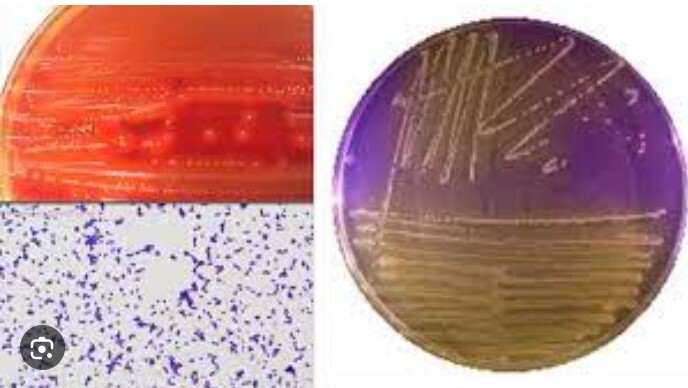
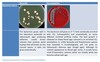
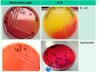

Identify Staphylococci in culture and in cytology of a sample ?

Staphylococcus is a gram positive coccus.
- Divides in all planes forming grape like clusters
- Well adapted to life on land, with a thick peptidoglycan outer membrane which provides them with environmental resistance
- Is a halophile
- Facultatively anaerobic
- Catalase positive
- Will grow in a saline environment = halotolerant
- The pathogenic staphylococci usually produce the enzyme coagulase
Order Bacillales – Family Staphylococaceae (essentially marine bacteria) – Genus Staphlococcus; Gemella
The members of the genus Staphylococus are non-motile, nonsporulating, gram positive cocci
Occurring in clumps

Identify potential sources of pathogenic staphylococci ?

Staphylococci are commensals on the skin and mucosa of all animals and people
Skin and mucosal microflora
- Can survive in dry environments eg clothing for up-to 3 months
- Pathogenic staphylococci are only a small part of the normal skin flora and oral – upper respiratory microflora, however, due to their ability to cause disease they are the most common cause of opportunistic infections in traumatic lesions of the skin and mucosae
They are common opportunistic pathogens of the skin and subcutaneous tissue

List the pathogenic staphylococci and the important diseases/s that each causes in animals ?

Pathogenic strains of staphlococci and the diseases they cause.
S. aureus
S. pseudintermedius
S.hyicus
Staphylococcus aureus – the golden grape cluster berry
S. Aureus is the most common of all the pathogenic staphylococci in animals causing pyogenic (production of pus) infections of the skin and related structures.
- usually initiated by traumatic wounds
- once established it may spread from these sites causing systemic infections, septic arthritis and osteomyelitis
- contagious with animal to animal, zoonotic transmission or even reverse zoonosis
MRSA = methicillin resistant staphylococci can be transmitted from animals to/from people
- Many published examples with MRSA in the nasopharynx of pigs resulting in mastitis in cattle
- Transmission = is by contact with either infected animals or with objects that have been in contact with infected animals (hand + hair clippers)
Osteomyelitis = inflammation of the bone or bone marrow
Staphylococcus pseudintermedius
S. pseudintermedius is a skin and mucosa commensal found in canids and is the most common cause of skin associated infections in dogs, cats and occasionally other animals/people.
- pyoderma, otitis externa (redness and swelling of the ear canal), MRSP
- difficult to distinguish within the laboratory from S. aureus
Staphlococcus Hyicus (Pig staphylococcus)
S.hyicus is the cause of exudative epidermitis or greasy pig disease
- may also affect poultry and rarely other animals

List the first line antibiotics that are effective against this genus and explain the importance of methicillin-resistant staphylococci ?

Amoxycillin potentiated with clavulanic acid = the antibiotic of choice
- Potentiated beta lactam drugs
- Most staphylococcus in companion animals is resistant to amoxycillin alone
- For skin infections cephalexin
- For livestock a procaine penicillin (long acting penicillin G), in horses a penicillin-gentamicin combination is used
Penicillin’s are highly synergistic with aminoglycosides and therefore in serious infections a combination of amoxicillin-gentamicin is often administered

Name and describe the function of important Staphylococcal toxins (6)?

To establish themselves pathogenic staphylococci produce a number of virulence factors dependant on their species and strain. (6)
Adhesins = binds to fibrin, fibronectin damaged tissue
Invasins Alpha and Beta toxins = hyaluronidase, protease, lipase enzymatic breakdown of DNA
Alpha toxin = porin toxin
Exfoliative toxin = Protease
breaks down desmoglein – 1 in the skin. Causes a bulla formation and skin sloughing
Superantigen = TSST-1 enterotoxin binds with MHC2 on antigen binding cells results in non specific T cell activation with subsequent release of cytokines
Immune system modulators = leukotoxin, protein A surface binding protein.
IgG binding protein at Fc region stimulates proliferation and apoptosis of some B lymphocytes microcolony formation.
Immune protection = catalase antioxidant and peroxidase respectively

- Review the cause, transmission, predisposing factors, pathogenesis, diagnosis and control of greesy pig disease ?

Staphylococcus hyicus is a contagious skin disease of predominantly piglets (greasy pig)
Cause = Staphylococcus hyicus
Transmission = This bacterium reaches high numbers in the sows vagina prior to partus and then colonises the skin and oral cavity of piglets during birth
Exudative dermatitis, it manifest as an explosive out break lasting for about 3 months. The affected pigs grow slowly and are susceptible to secondary infections.
Clinical signs = Crust formed by exudate and proliferating epidermal cells
- Skin starts by reddening, becomes brown and later develops a greasy texture
- Out breaks are frequent following weaning and may cause up-to a 15% mortality
Predisposing factors = The disease only manifests when there is trauma to the skin, biting, rough floors or straw bedding
- High infection rates with irritant skin mites
- Circovirus2 and parvovirus predispose the piglets hence it is more common to see in 1-5 week old piglets
Pathogenesis
- S. hyicus is a skin commensal proliferates on the skin in a humid warm environment.
- It will invade damaged skinproliferate and produce exotoxins
- Most important = exfoliative toxins (exhA, exhB, exhC and exhD) which destroys desmoglein 1 found in the intracellular cement of cells stratum spinosum and cleaves the cells.
- Elicits a severe inflammatory response within the skin
- Exudation of a protein rich fluid – which if severe enough can lead to weight loss and dehydration
- Pigs that die often have secondary bacterial infections especially of the kidneys and lungs
Diagnosis
Clinical signs (exudative dermatitis) and history piglets 1-5 weeks of age or at weaning
Control / prevention
- Chlorohexidine wash or novobiocin intramammary preparation with mineral oil sprayed directly onto the skin
- Topical antibiotics
- Prevent injury = upgrade surfaces, teeth clipping, tail-docking
- Iron injections
- Ensure cleanliness of farrowing crate and ensure disinfection between farrowing
- Treat for mange
- All in, all out policy
- autogenous vaccine of the sow 2-4 weeks prior to farrowing

Explain the predisposing factors and the clinical signs of Staphylococcus pseudintermedius infections in dogs?

Staphylococcus pseudintermedius is an unpigmented, coagulase positive Staphylococcus that is found in the skin and mucous membranes of dogs (all canids), and cats.
* Potentially zoonotic
* primary cause of skin infections and such as pyoderma as well as acute ear infections.
* clinical signs depend on the lesions depth and can be as mild as scaling to a papule and pustule formation, ulceration and exudation
* -deep pyodermas are the hardest of all skin infections to treat
* also affects other organs such as the bladder causing cystitis and bone causing osteomyelitis
Predisposing factors
Infection occurs when there is an overgrowth of mainly S.pseudintermedius
- Wet and moist areas have a higher number of bacteria and are more likely to become infected
- Any skin disease eg demodicosis causing itchiness that changes normal skin morphology from desert like to moist
- Immunosuppression
- Follicular hyperkeratosis, demodicosis or a foreign body
- It may occur secondarily to a superficial pyoderma (caused by allergy’s, seborrhoea, parasitic infections etc)
- German shepherds and Bull terriers have a genetic predisposition to disease
Pathogenesis
Deep pyoderma includes folliculitis, furunculosis, abscesses or cellulitis where there is an accumulation of pus within the dermis and subcutis
* Localised hair loss
* Pustules
* epidermal collarettes
* ulceration
* haemorrhagic bullae
* nodules

Distinguish between the staphylococci and streptococci using key morphological and biochemical features

Streptococci
* Gram positive, non-motile, non-spore forming, facultatively anaerobic cocci
* Form chains
* Catalase negative
* Tend to not develop resistance against antibiotics
* Beta-haemolysis (complete clearing of blood agar due to the destruction of red blood cells), some undergo alpha haemolysis P.Pneumonia greening on blood gar
* They are apart of the Lactic acid group (also includes Enterococcus, Lactobacillus)
Describe the Lancefield grouping scheme and how its works?

Streptococci
Lancefield grouping scheme
Latex agglutination test
Beta-haemolytic streptococci can be grouped into Lancefield types based on antibodies to carbohydrates/antigens (C-substance) in the streptococcal outer membrane.
(Group D)
* Requires antigen detection test = latex agglutination test is used
* Clumping of the blue latex particles indicates that agglutination antibodies have attached to the outer membrane of a homologous antigen (+ve).
List of potential diseases
- s. agalactiae bovine mastitis
- S. equi equi strangles
- S. equi zooepidemicus pyogenic infections and endometritis
- S. suis pyogenic infections + septicaemia + meningoencephalitis
- S. cani
- S. iniae fish septaceamia
- S. uberis mastitis

BE ABLE TO IDENTIFY POTENTIAL SOURCES OF PATHOGENIC STREPTOCOCCI AND ENTEROCOCCI ?

Streptococci
Streptococci are normal flora or the skin and mucous membranes of the mouth, nose and throat as well as external genitalia.
Some pathogenic streptococci have specific niches on the body. For example, Streptococcus equi subsp. equi, the agent of strangles, is found in the nasal cavity or guttural pouch of carrier horses, and Streptococcus uberis is a commensal within the teat canal of cows.
Under ideal conditions i.e. kept moist in mucus secretions, streptococci can last 7 to 9 weeks in the environment.
Enterococci are commensals within the intestinal tract.

LIST AND DESCRIBE THE FUNCTION OF IMPORTANT STREPTOCOCCAL VIRULENCE FACTORS ?

Streptococci cause pyogenic (pus causing) infections of the skin, udder, ear, upper and lower respiratory tract.
- Lipotechoic acid LTA,
Adhesin attached to the cell membrane acts in adhesion molecule and stimulates inflammation - Hyaluronidase, streptokinases
Invasin causing connective tissue break - Superantigen non specific T-cell mitogens
By interacting with a large number of T cell receptors causing activation (outside of the antigen recognition site) causing massive cytokine release and shock - M protein
Immune modulator = blocks complement binding, antiphagocytic and can mimic host cell surface proteins resulting in autoimmunity. - Streptolysin S leukocidins (kills leucocytes).
- Hyaluronic acid capsule
Immune system modulators = acts as a poor antigen in host connective tissue and allows micro colony formation.

LIST THE ANTIBIOTICS THAT ARE EFFECTIVE AGAINST THE STREP FAMILY ?
Streptococci treatment
Use either penicillin or amoxycillin to treat streptococcal infections
- Most effective especially early on in the disease is penicillin
- For oral therapy amoxicillin is effective
- Lipid soluble trimethoprim sulphonamides may work better for animals with long standing infections and abscesses which are not easily accessible (lincosamides and macrolides)
Note = High risk that these animals may develop toxic shock syndrome
Enterococcus is much more prone to antibiotic resistance
Review the cause, transmission and predisposing factors of strangles in horses?

One of the most commonly diagnosed and important contagious bacterial diseases of horses in Australia
Cause = Streptococcus equi equi
- This is a notifiable disease Victoria only (the disease is endemic in Australia)
Transmission = directly through inhalation of sneezed bacteria; or nasal abscess contact
- Possible transmission through contaminated stables, equipment or water (fomites)
- Highly contagious
Predisposing factors
- Communal drinking sources
- Population density
- mobility

Describe the pathogenesis and clinical signs of strangles in horses ?

Strangles
Pathogenesis
Within three hours of transmission it attaches to the tonsillar crypt and follicular cells of the soft palate through surface lipotechoic acids and SEM binding proteins.
SEE produces a capsule and SEM protein
- this works by actively binding fibrinogen and IgG which inhibits deposition of C3b on the bacterial cell surface. This results in a antiphagocytic action.
SEE then divides and spreads to other lymph nodes (mandibular and retropharyngeal). The dividing bacteria stimulate an inflammatory response resulting in fever and abscessation of the lymph nodes.
Rupture of the retropharyngeal abscesses can lead to bronchopneumonia or guttural pouch empyema (pockets of pus).
Guttural pouch empyema may result in persistent carrier horses.
Clinical signs
- first sign pyrexia (fever), this is when the horse becomes infectious to other horses (18days)
- purulent nasal discharge
- lymph nodes of the head and neck will develop abscesses
- the abscesses once ripe will rupture either to the outside or leading to the purulent nasal discharge.
- marked swelling of the neck causing breathing difficulties hence the name strangles
Shedding of bacteria lasts 2-3 weeks

Describe the very serious concerns which surround strangles ?

The possible complications of strangles
- Persistently infected horses / guttural pouch empyema
- the bacteria may decimate in the blood stream and lodge in other tissues of the body causing metastatic abscessation.
- this condition requires long term antibiotic therapy and often results in death
- bastard strangles - Type three hypersensitivity
Three to four weeks after infection with SEE may trigger an immune complex reaction.
- usually in horses with high titres
- pupura haemorrhagica (swelling of the blood vessels, head, legs and underbelly).
- hypersensitised horses produce high quantities of IgA which results in generalised vasculitis leading to oedema and haemorrhages.
- fatal if left untreated

Describe how you would go about diagnosing and treating a case of strangles ?

Strangles
Diagnosis
- qPCR (quantitative)
- bacterial culture of nasal swabs or abscess exudates are used to diagnose clinical cases.
- Serology is used to determine exposure with high titres found in carrier horses
Detection of carrier animals
- Infection occurs through abscessed retropharyngeal rupture and drainage into the guttural pouches
- 50% have a chronic cough
- Pus in guttural pouch if not drained will dry into chondroids (dry and hard).
- There is reluctance to scope guttural pouches so most cases of guttural pouch empyema are carried out using nasal fluids.
Control
- Quarantine horses that are known to be infected for a minimum period of 21 days
- twice daily rectal temperature check of unaffected horses / pyrexia precedes shedding
- Horses inContact with those infected moved to an orange zone, no known contact green zone
(take rectal temperatures to determine infection twice daily)
- Avoid movement off property
- Warm compresses to the abscess will assist with their ripening, once ripened can be lanced
- Antibiotics are controversial as they may extend the time required to heal and prevent the build up of immunity
- Treat sick horses last eg fomites
- Clean disinfect stables and equipment
- Can vaccinate unaffected horses

Describe the transmission and predisposing factors of Streptococcus suis infections in pigs ?

Streptococcus suis
Transmission
- Carried on the tonsils of pigs and external genitalia of sows
- Usually by droplets of the oral and respiratory secretions of carrier pigs or birth
- Flies and humans may mechanically transmit the disease to neighbouring pig houses/farms
Predisposing factors
- Disease in pigs is usually precipitated by stress ie weaning, mixing of age groups, overcrowding
- Other infections may increase susceptibility

Describe the pathogenesis, diagnosis and control of Streptococcus suis in pigs ?

Streptococcus suis in pigs
Pathogenesis
The only difference discovered between virulent strains and non-virulent strains is that virulent strains may survive within the phagolysosome of macrophages.
Clinical signs
- Serotype one Polyarthritis and meningitis in 10-14 day old piglets
- Serotype two is more common and results pneumonia and sepsis in weaned and grower pigs (serotype two is zoonotic)
- Sporadic and sudden, explosive out-breaks which may also stop suddenly
Diagnosis
- History, clinical signs
- Isolation and serotyping of the infectious agent
- Evaluation of microscopic lesions
Control
- Animals respond well to penicillin treatment

Describe the pathogenesis and clinical signs of Streptococcus canis ?

Streptococcus canis
Streptococcus canis is a normal commensal in the mucosa of dogs.
- Produces a unique M protein that is antiphagocytic and causes a variety of localised infections including abortions, vaginitis, cystitis and bronchopneumonia
- It may decimate from the site of infection to the rest of the body to cause septicaemia
- In dogs it is frequently identified in infections of the external ear and skin
Rare strains of S. canis are infected with a bacteriophage DNA that encodes for superantigens – which cause the development of streptococcal toxic shock syndrome
- fluroquinolones may regulate expression of this gene
Review the cause, transmission, predisposing factors, pathogenesis, diagnosis and control of Streptococcus iniae infections in fish ?

Streptococcal sepsis in fish Streptococcus iniae
The most important bacterial infection of farmed tropical freshwater and marine fish
Fish usually become infected through cannabilism of affected fish
* High water temperatures increase the risk of disease + stressed fish
Pathology
* Bacterial septicaemia and meningoencephalitis resulting in the loss of orientation, lethargy, anorexia, ulcers, exophthalmia and erratic swimming
* New outbreaks within naïve populations of fish may result in a 50% mortality
* Zoonotic sepsis toxic shock n fisherman
Streptolysin S like toxin
The prime toxin responsible for cell destruction in numerous tissues
Beta haemolytic, dose not group in the Lancefield grouping scheme and is CAMP positive
Control
Control measures may include reducing the feed to decrease bacteria ingestion, reducing water temperature and decreasing of the stocking density
- Many farmed species are vaccinated by bath immersion or by intraperitoneal injection affording 6 months of protection
(must contain the serotype on farm to be affective). - Susceptible to penicillin antibiotics

Define mastitis and explain the importance of mastitis to the dairy industry

Mastitis
Is defined as inflammation of the mammary gland usually in response to a bacterial infection. Other infectious causes include fungal, algal or viral.
It may manifest as peracute (severe short duration), acute, subacute (inbetween) or chronic
Or subclinical (no clinical signs)
The importance of mastitis to the dairy industry
- loss in milk production
- increase in discarded downgraded milk
- early culling of cows (need to replace sooner)
- treatment expenses
- reduction of breed performance
- Painful to the cow may prevent suckling of young
- antibiotic/pathogenic residues may cause diarrhoea in the calf.
-The presence of bacteria in milk is a public health risk, as it may result in disease in people

Explain how the bacteria infect the udder and overcome udder defences ?

Bacteria usually infect the udder by the teat canal. The teat is an invagination of the skin and is lined with squamous cell epithelium.
A healthy udder
* During milking the teat lining is continually sloughed off and replaced
* This process flushes out the bacteria trapped in cells during milking
- the narrow canal is surrounded by a thick muscular layer known as the teat sphincter which serves to exclude bacteria.
(musculoelastic layer = Rosette of Furstenburg)
Reason for disease
- During the dry period the udder becomes more susceptible to infection with the keratin plug being the main line of defence.
- during milking the teat may evaginate allowing bacteria in
- bacteria may be propelled within the teat canal by vaccum fluctuations of the milking machine
- to long of a vacuum by the milking machine can result in congestion and oedema allowing the entry of bacteria
Once the bacteria have breached the teat defences as little as 100 bacterial cells can result in mastitis.

Why is lactoferrin important in defence of the udder in dairy cows ?

Lactoferrin
Lactoferrin in milk bind iron making it unavailable to bacteria.
It also binds to LPS (Gram negative bacterium) causing peroxide formation and damage to the bacterial cell membrane.
Lactoferrin also protects cell membranes from viral attack and will oxidise RNA.
However bacteria in high numbers can overcome lactoferrin

What factors could predispose to mastitis ?

Factors which predispose to mastitis
Any activity that leads to teat damage and loss of its ability to act as a barrier will allow the entry colonisation and invasion of pathogens
- udder anatomy and physiology
- stage of lactation (udder oedema early lactation in heifers)
- milkers
- milking equipment
- environment (faecal contamination muddy)
- teat damage by injury or viruses